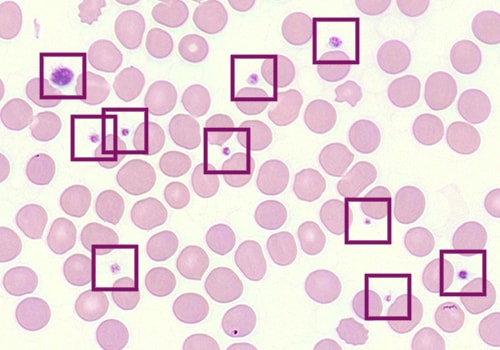
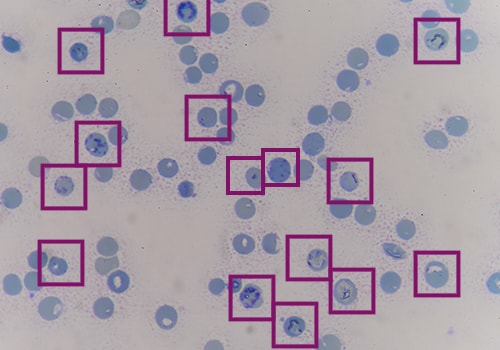

References:
1. Bowles KM, Cooke LJ, Richards EM, Baglin TP. Platelet size has diagnostic predictive value in patients with thrombocytopenia. Clin Lab Haematol. 2005;27(6):370-373. doi:10.1111/j.1365- 2257.2005.00726
2. Numbenjapon T, Mahapo N, Pornvipavee R, et al. A prospective evaluation of normal mean platelet volume in discriminating hyperdestructive thrombocytopenia from hypoproductive thrombocytopenia. Int J Lab Hematol. 2008;30(5):408-414. doi:10.1111/j.1751- 553X.2007.00969
3. Saran K, Vidya K, Seema K, Prasad A, Prakash J. Study of platelet indices and their role in evaluation of thrombocytopenia. J Family Med Prim Care. 2022;11(10):6236-6242. doi:10.4103/jfmpc.jfmpc_460_22
4. Rodriguez BAT, Johnson AD. Platelet Measurements and Type 2 Diabetes: Investigations in Two Population-Based Cohorts. Front Cardiovasc Med. 2020;7:118. doi:10.3389/fcvm.2020.00118
5. Zhu X, Cao Y, Lu P, et al. Evaluation of platelet indices as diagnostic biomarkers for colorectal cancer. Sci Rep. 2018;8(1):11814. doi:10.1038/s41598-018-29293
6. Sileshi B, Urgessa F, Wordofa M. A comparative study of hematological parameters between hypertensive and normotensive individuals in Harar, eastern Ethiopia. PLoS ONE. 2021;16(12):e0260751. doi:10.1371/journal.pone.0260751
7. Ding L, Sun L, Wang F, Zhu L, Zhang T, Hua F. Clinical significance of platelet volume and other platelet parameters in acute myocardial infarction and stable coronary artery disease. Arq Bras Cardiol. 2019;112(6):715-719. doi:10.5935/abc.20190058
8. Coskun A, Yavasoglu I, Sargin G, et al. The role of mean platelet volume in patients with non- specific abdominal pain in an emergency department. Prz Gastroenterol. 2015;10(3):156-159. doi:10.5114/pg.2015.49042
9. Bowles KM, Warner BA, Baglin TP. Platelet mass has prognostic value in patients with myelodysplastic syndromes. Br J Haematol. 2006;135(2):198-200. doi:10.1111/j.1365- 2141.2006.06246
10. Harrison P, Price J, Didembourg M, et al. Feasibility of a mean platelet volume standard: an international council for standardization in hematology (ICSH) inter-laboratory study. Platelets. 2022;33(8):1159-1167. doi:10.1080/09537104.2022.2060956
11. Harrison P, Goodall AH. Studies on Mean Platelet Volume (MPV) - New Editorial Policy. Platelets. 2016;27(7):605-606. doi:10.1080/09537104.2016.1225467
12. Beyan C, Beyan E. Were the measurements standardized sufficiently in published studies about mean platelet volume? Blood Coagul Fibrinolysis. 2017;28(3):234-236. doi:10.1097/MBC.0000000000000586
13. Riva G, Castellano S, Nasillo V, et al. Monocyte Distribution Width (MDW) as novel inflammatory marker with prognostic significance in COVID-19 patients. Sci Rep. 2021;11(1):12716. doi:10.1038/s41598-021-92236-6
14. Hossain R, Ayub S, Tarabichi Y. Monocyte distribution width adds prognostic value in detection of COVID-19 respiratory failure. Int J Lab Hematol. 2022;44(2):e64-e66. doi:10.1111/ijlh.13712
15. Malinovska A, Hinson JS, Badaki-Makun O, et al. Monocyte distribution width as part of a broad pragmatic sepsis screen in the emergency department. Journal of the American College of Emergency Physicians Open. 2022;3(2):e12679. doi:10.1002/emp2.12679
16. Piva E, Zuin J, Pelloso M, Tosato F, Fogar P, Plebani M. Monocyte distribution width (MDW) parameter as a sepsis indicator in intensive care units. Clin Chem Lab Med. 2021;59(7):1307- 1314. doi:10.1515/cclm-2021-0192
17. Hausfater P, Robert Boter N, Morales Indiano C, et al. Monocyte distribution width (MDW) performance as an early sepsis indicator in the emergency department: comparison with CRP and procalcitonin in a multicenter international European prospective study. Crit Care. 2021;25(1):227. doi:10.1186/s13054-021-03622-5
18. Woo A la, Oh DK, Park C-J, Hong S-B. Monocyte distribution width compared with C-reactive protein and procalcitonin for early sepsis detection in the emergency department. PLoS ONE. 2021;16(4):e0250101. doi:10.1371/journal.pone.0250101
19. Lin H-A, Lin S-F, Chang H-W, Lee Y-J, Chen R-J, Hou S-K. Clinical impact of monocyte distribution width and neutrophil-to-lymphocyte ratio for distinguishing COVID-19 and influenza from other upper respiratory tract infections: A pilot study. PLoS ONE. 2020;15(11):e0241262. doi:10.1371/journal.pone.0241262
20. Agnello L, Bivona G, Vidali M, et al. Monocyte distribution width (MDW) as a screening tool for sepsis in the Emergency Department. Clin Chem Lab Med. 2020;58(11):1951-1957. doi:10.1515/cclm-2020-0417
21. Marcos-Morales A, Barea-Mendoza JA, García-Fuentes C, et al. Elevated monocyte distribution width in trauma: An early cellular biomarker of organ dysfunction. Injury. 2022;53(3):959-965. doi:10.1016/j.injury.2021.11.026
22. Crouser ED, Parrillo JE, Seymour CW, et al. Monocyte Distribution Width: A Novel Indicator of Sepsis-2 and Sepsis-3 in High-Risk Emergency Department Patients. Crit Care Med. 2019;47(8):1018-1025. doi:10.1097/CCM.0000000000003799
23. Crouser ED, Parrillo JE, Seymour C, et al. Improved early detection of sepsis in the ED with a novel monocyte distribution width biomarker. Chest. 2017;152(3):518-526. doi:10.1016/j.chest.2017.05.039
24. Ognibene A, Lorubbio M, Magliocca P, et al. Elevated monocyte distribution width in COVID-19 patients: The contribution of the novel sepsis indicator. Clin Chim Acta. 2020;509:22-24. doi:10.1016/j.cca.2020.06.002
25. Shalova IN, Lim JY, Chittezhath M, et al. Human monocytes undergo functional re-programming during sepsis mediated by hypoxia-inducible factor-1α. Immunity. 2015;42(3):484-498. doi:10.1016/j.immuni.2015.02.001
26. Lazarova E, Pradier O, Cotton F, Gulbis B. Automated reticulocyte parameters for hereditary spherocytosis screening. Ann Hematol. 2014;93(11):1809-1818. doi:10.1007/s00277-014-2127-8
27. Nair SC, Arora N, Jain S, Inbakumar D, Mammen J, Sitaram U. Mean reticulocyte volume enhances the utility of red cell mean sphered cell volume in differentiating peripheral blood spherocytes of hereditary spherocytosis from other causes. Indian J Pathol Microbiol. 2015;58(3):307-309. doi:10.4103/0377-4929.162836
28. Xu Y, Yang W, Liao L, et al. Mean reticulocyte volume: a specific parameter to screen for hereditary spherocytosis. Eur J Haematol. 2016;96(2):170-174. doi:10.1111/ejh.12563
29. Liao L, Xu Y, Wei H, et al. Blood cell parameters for screening and diagnosis of hereditary spherocytosis. J Clin Lab Anal. 2019;33(4):e22844. doi:10.1002/jcla.22844
30. Wu Y, Liao L, Lin F. The diagnostic protocol for hereditary spherocytosis-2021 update. J Clin Lab Anal. 2021;35(12):e24034. doi:10.1002/jcla.24034
31. Arora RD, Dass J, Maydeo S, Arya V, Kotwal J, Bhargava M. Utility of mean sphered cell volume and mean reticulocyte volume for the diagnosis of hereditary spherocytosis. Hematology. 2018;23(7):413-416. doi:10.1080/10245332.2018.1423879
32. Crispin PJ, Sethna F, Andriolo K. Red cell and reticulocyte parameters for the detection of iron deficiency in pregnancy. Clin Lab. 2019;65(11). doi:10.7754/Clin.Lab.2019.190427
33. Rodrigues A, Ortega C, Santos L, et al. Clinical utility of Beckman-Coulter Gen’s reticulocyte analysis in the study of anemia of chronic disease (ACD). Lab Hematol. 2007;13(3):85-92. doi:10.1532/LH96.07007
34. Buttarello M. Laboratory diagnosis of anemia: are the old and new red cell parameters useful in classification and treatment, how? Int J Lab Hematol. 2016;38 Suppl 1:123-132. doi:10.1111/ijlh.12500
35. Piva E, Brugnara C, Spolaore F, Plebani M. Clinical utility of reticulocyte parameters. Clin Lab Med. 2015;35(1):133-163. doi:10.1016/j.cll.2014.10.004
 English
English